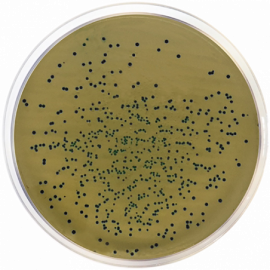

新入荷
再入荷
【期間限定送料無料】 ホメオパシーマテリアメディカ大全1(Abel-Agar) | |本 啓二 森井 その他
 タイムセール
タイムセール
終了まで
00
00
00
999円以上お買上げで送料無料(※)
999円以上お買上げで代引き手数料無料
999円以上お買上げで代引き手数料無料
通販と店舗では販売価格や税表示が異なる場合がございます。また店頭ではすでに品切れの場合もございます。予めご了承ください。
商品詳細情報
| 管理番号 |
新品 :44977225059
中古 :44977225059-1 |
メーカー | b563201486dc | 発売日 | 2025-05-24 02:53 | 定価 | 10000円 | ||
|---|---|---|---|---|---|---|---|---|---|
| カテゴリ | |||||||||

![PEARLY GATES パーリーゲイツ 2023年モデル インナー付 蓄熱ブルゾン スニードジャック ホワイト系 6 [240101336713] ゴルフウェア メンズ](https://auctions.c.yimg.jp/images.auctions.yahoo.co.jp/image/dr000/auc0101/user/8e9a04ff8211ad81a02f71c5a44c99781f196892a80a89001a4259a60868183f/i-img1000x1000-173769093986063trxdf3678.jpg)





